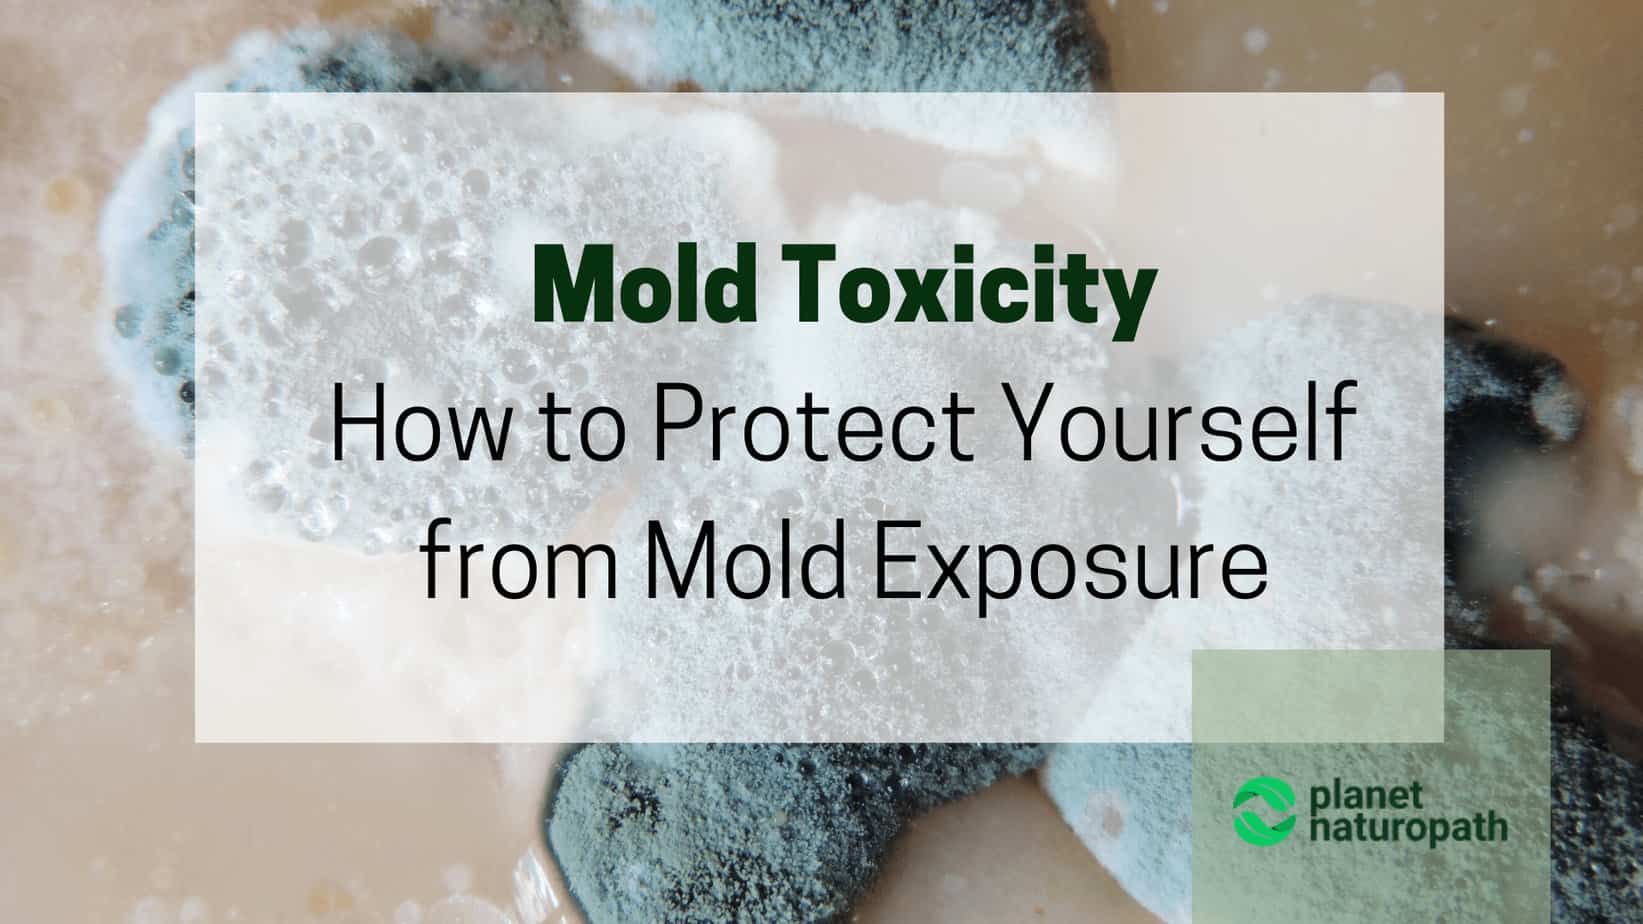
Mold-Toxicity-How-to-Protect-Yourself-from-Mold-Exposure

Mold Toxicity: 9 Steps to Protect Yourself from Mold Exposure
Mold is a ubiquitous fungus that can be found almost anywhere on the planet, indoors and outdoors. In general, normal amounts of mold in the environment won’t lead to mold toxicity. However, an overgrowth of mold in your house or place of work can negatively impact your health levels and cause a wide range of symptoms.
If you’ve been experiencing any persistent symptoms like fatigue, brain fog, wheezing, itchy skin or nose stuffiness, you should definitely check for mold. You may be one of the many people unknowingly suffering from toxic mold.
In this article, I’ll cover all the mold symptoms in humans, what type of mold is your enemy and how to test for mold toxicity, the best treatment options, and how to control mold growth in the home.
Table Of Contents
- What Are The Symptoms Of Mold Toxicity?
- Who Is Most Susceptible To Mold Toxicity
- Mold Vs Mildew: Know Your Enemy
- What Does Mold Look Like?
- Mold Inspection: How To Test Your Home For Mold?
- When To Test For Mold?
- Types Of Tests For Mold
- Common Mistakes When Searching For Mold
- How To Remove Mold On Your Own?
- When To Hire Professionals For Mold Remediation?
- Testing Your Health For Mold
- HLA-DR Testing For Mold Sensitivity
- Steps To Prevent Mold Growth
What Are The Symptoms Of Mold Toxicity?
Mold toxicity is also known as mold poisoning or mycotoxicosis.
Mycotoxicosis is a condition caused by exposure to mycotoxins, which are toxic substances produced by certain types of mold (fungi).
These toxins can contaminate food, air, or surfaces and pose a health risk to humans and animals when ingested, inhaled, or come into contact with the skin.
Mycotoxins are produced by molds under specific conditions, particularly in environments with high moisture and temperature, which facilitate mold growth.
There are many types of mycotoxins, with varying effects on health, and their impact can range from mild to severe, depending on the type of toxin, the duration of exposure, and the individual’s health and susceptibility.
Some well-known mycotoxins include aflatoxins, ochratoxins, trichothecenes, and zearalenone, each associated with different health risks.
Health Effects Of Mycotoxicosis
The symptoms and health effects of mycotoxicosis can vary widely, but some common issues include:
- Respiratory problems: Difficulty breathing, wheezing, and coughing.
- Neurological issues: Headaches, dizziness, and, in severe cases, cognitive impairments and neurological damage.
- Immune system suppression: Increased susceptibility to infections and possibly contributing to autoimmune diseases.
- Gastrointestinal symptoms: Nausea, vomiting, diarrhea, and abdominal pain.
- Liver and kidney damage: Some mycotoxins are hepatotoxic (toxic to the liver) or nephrotoxic (toxic to the kidneys), leading to organ damage and dysfunction.
- Allergic reactions and skin irritation: Rashes, itching, and allergic responses.
- Cancer: Prolonged exposure to certain mycotoxins, such as aflatoxins, is linked to an increased risk of some cancers, notably liver cancer.
While key symptoms such as respiratory issues, neurological symptoms, and skin irritation are the most noticeable, there’s a breadth of additional signs and potential long-term health implications that are important to acknowledge.
Expanded Symptoms Of Mold Toxicity
Immune System Suppression
Prolonged exposure to mold may weaken the immune system, making it harder for the body to fight off infections and diseases. This can result in an increased susceptibility to viral and bacterial infections, and in some cases, may lead to chronic immune dysfunction.
Digestive Issues
Exposure to mold toxins can affect the digestive system, leading to symptoms such as nausea, vomiting, diarrhea, and abdominal pain. Some individuals may experience persistent digestive disturbances, which can complicate the absorption of nutrients and lead to weight loss or malnutrition.
Joint Pain and Inflammation
Mold exposure has been linked to inflammatory responses that can result in joint pain, stiffness, and swelling. This can mimic rheumatic diseases and make diagnosis and treatment challenging.
Cognitive and Emotional Effects
Beyond the well-documented “brain fog,” individuals exposed to mold may experience significant cognitive decline, memory loss, anxiety, depression, and mood swings. The impact on mental health can be profound and debilitating.
Chronic Fatigue Syndrome
A condition characterized by extreme fatigue that doesn’t improve with rest can also be a symptom of mold toxicity. This fatigue often limits daily activities and can be accompanied by pain, headaches, and sleep disturbances.
Sensitivity to Chemicals and Smells
Individuals suffering from mold toxicity may develop heightened sensitivity to chemicals, perfumes, smoke, and other environmental irritants, leading to allergic reactions or exacerbation of existing symptoms.
Who Is Most Susceptible To Mold Toxicity
Certain individuals are more sensitive to mold exposure and are at higher risk of experiencing the symptoms of mold intoxication. These groups include:
Infants and Children
Their immune systems are still developing, and their bodies are more susceptible to environmental pollutants, including mold spores and toxins. Children may also spend more time closer to the ground where mold spore concentrations can be higher, especially indoors.
Elderly People
Aging can lead to a natural decline in the immune system’s functionality, making the elderly more vulnerable to mold-related health issues. They might also have underlying health conditions that could be exacerbated by mold exposure.
People with Weakened Immune Systems
Individuals with compromised immune systems, due to conditions like HIV/AIDS, cancer treatments such as chemotherapy, or the use of immunosuppressive drugs for organ transplants or autoimmune diseases, are at increased risk. Their bodies are less capable of fighting off the effects of mold exposure.
People with Chronic Respiratory Conditions
Those suffering from chronic respiratory diseases such as asthma, chronic obstructive pulmonary disease (COPD), or cystic fibrosis are more likely to experience aggravated symptoms upon mold exposure. Mold spores can trigger respiratory symptoms, including wheezing, difficulty breathing, and coughing.
People with Mold Allergies
Individuals allergic to mold can have more severe reactions when exposed to mold spores. Symptoms can range from sneezing, runny nose, and itchy eyes to more severe asthma attacks.
People with a Genetic Predisposition to Mold Toxicity
Research suggests that certain individuals have a genetic predisposition that makes them more susceptible to mold toxicity. For example, variations in the HLA-DR gene have been linked to increased sensitivity to mold and its toxins.
People with Pre-existing Skin Conditions
Individuals with conditions like eczema or psoriasis may find that mold exposure exacerbates their skin symptoms, leading to increased irritation, itching, or flare-ups.
Understanding who is at greater risk can help in taking appropriate measures to minimize exposure and protect those who are most vulnerable to the adverse health effects of mold intoxication. If you or someone you know falls into these categories, it’s important to be vigilant about mold prevention and remediation in living and working environments.
Mold Vs Mildew: Know Your Enemy
Mold and mildew are two fungi that can invade your house, however, there is a big difference between them.
Mildew is less troublesome and can be easily removed. Usually, you can find it in the corner of a shower or on the bathroom tile and clean it with the help of bleach or vinegar.
Mold is the real evil, which is harder to detect and to fight, it can be in your house for years causing health problems. It can have a musty odour, or have no smell at all, and can grow in different colours, from red to green and may look like dirt, which you may ignore at first. If you don’t detect the mold growth in its early stage, cleaning the house out from these fungi could be challenging and you might need the help of professionals.

What Does Mold Look Like?
There are over 1000 mold species but some mold is more common to be found in a home or other indoor environment. You can encounter molds with different characteristics, hiding inside upholstery, near condensation-laden pipes, under insulation, and behind wallpaper, but let’s focus on the most common unwanted guests.
There are six main indoor molds that can wreak havoc on your health:
Mold Inspection: How To Test Your Home For Mold?
“Is my house making me sick?” – a question that bothers many people with respiratory problems, allergies, rashes, fatigue and brain fog, and other symptoms of mold sickness. If you suspect that your home environment is the reason for your health problems, it is high time to check your home for mold.
Step 1
Check out basements wall, laundry rooms, air conditioning systems, bathroom, underneath the sinks, windowsills, closets, refrigerator door seals and drain pans, and closets. Search not only for black or green patches but do the sniff test. The musty smell can help you detect the source of mold growth, but be aware sometimes there is no odour.
Step 2
Look for causes of mold growth, such as broken pipes, a leak, past flooding, lack of ventilation, old food or wood furniture. Knowing the cause of possible mold growth will help detect this insidious intruder faster.
Step 3
Don’t ignore your symptoms. If you start coughing, sneezing, or wheezing when you enter the room, it could be caused by spores or mycotoxins produced by mold. Sometimes mold can be hidden behind walls and difficult to detect without the help of experts.
As soon as you have detected the mold, get rid of it. Don’t postpone it till its too late, especially if you’ve managed to detect the toxic mold like Stachybotrys. Long exposure to toxic mold can cause life-threatening symptoms.
If you have the symptoms of toxic mold you should not be the one that remediates the mold as this can make your symptoms a lot worse. The best option is to get the help of mold experts.
For more information, make sure you check our in-depth article on How To Test Your Home for Mold!
When To Test For Mold?
Situation 1 – When Mold is Successfully Detected
If you have found mold, you may not waste time on testing but move to the removal stage.
Situation 2 – When Mold is Invisible
When you cannot find the mold but the smell is present, this is a case when testing is needed. Specific tests and assistance of professionals will eliminate the guesswork and help prevent health issues.
Types Of Tests For Mold

Air Testing For Mold
Air sampling assesses the concentration of mold spores in the air inside your home. The samples are taken from the air and carefully examined in the lab. The results will tell you whether the mold is the underlying cause of polluted indoor air and respiratory problems.
Surface Testing
Another way to detect mold is surface testing. It works simple, by swabbing and tape lifting you take samples from household surfaces for further examination in the lab.
For reliable results, don’t ignore organic surfaces like paper or wood paneling. Although this test won’t identify the spore concentration in the air, it will let you know the amount of mold growth spread around your home.
Note: The results of air and surface tests can vary because the amount of mold spores in the air and on the surface can change drastically at different times.
Bulk Testing
Bulk testing is about measuring a concentration of mold particles in your home. You just have to collect pieces of material from the home and bring them to a laboratory.
Small pieces of carpet, drywall, wallpaper, and wood are the best samples for mold testing.
The Environmental Relative Moldiness Index (ERMI)
The Environmental Relative Moldiness Index (ERMI) test is another option to assess “moldiness” in your house. It is just a single sample of dust from a home, however, this testing has certain advantages.
- The ERMI tests for 36 species, including water damage mold and common indoor molds.
- As far as the carpet dust is like storage of mold spores, ERMI is considered to be a more reliable tool for mold measurement than the air testing.
- Also, the dust sample will be analyzed using a mold-specific quantitative polymerase chain reaction (MSQPCR). This method guarantees precise results that you can compare to a national database.
To sum up, this test is a great tool that will give you a better picture of how moldy your house is.
Common Mistakes When Searching For Mold
- Relying only on mold tests. Visual inspection is extremely important before purchasing any test kits.
- Inspecting only ‘easy’ areas. To detect all the mold, it is important to check crawl spaces, basements, and on poured concrete slabs
- Ignoring Insulation. By not checking insulation properly, a source of not-visible mold contamination can remain undetected for years, which is quite dangerous for your health.
How To Remove Mold On Your Own?

If the affected area is not large and the mold is growing mostly on the easy-to-clean surfaces such as tile, you can handle this mold problem on your own. In this case, hiring professionals is not necessary unless you are sensitive to mold or have the symptoms of mold toxicity, cleaning the mold yourself could cause a flare-up.
All you need to remove mold:
- A commercial mold removal product
- Undiluted white vinegar
- A mixture of 1 cup of bleach per gallon of water (you can add a bit of dish soap for better results)
- Use an even mix of clear ammonia and water to remove mold spores; spay a moldy area with this mix, wait a few hours and then rinse and dry
- Make sure to get rid of porous materials with mold such as carpets
Note: When cleaning the mold on your own, it’s important to use mask, gloves, and goggles for your safety.
When To Hire Professionals For Mold Remediation?

Not always you can fight the mold with the help of bleach and soap. Here are the main situations:
- There is extensive mold growth in the home
- If a flood has caused serious damage, the mold overgrowth should be carefully checked and removed by professionals
- The mold has been detected in your HVAC system
- There is a musty smell of mold but you cannot detect the source
- You have a medical condition, such as asthma and would like to avoid mistakes and fully remove the mold from your home environment
Noteworthy:
- If you experience severe mold toxicity symptoms or suffer from a medical condition, such as asthma, it is not recommended to fight the mold on your own. This may just aggravate your symptoms and cause complications. Don’t hesitate to hire professionals for proper mold remediation.
- When the mold toxicity symptoms are unbearable, it won’t be a mistake to move some items out of your house to the storage or your parents’ garage temporarily or forever. Some of the problematic items that may worsen your mold sickness include computers, appliances, bedding, books, and upholstered furniture.

Testing Your Health For Mold
If you are experiencing symptoms of mold toxicity and would like to know for sure whether the possible mold exposure has affected your health, there are several tests that could be performed.
The Spirometric Test
This test helps measure lung function A decreased capacity of the lung function is one of the signs of asthma and mold poisoning.
Blood Test
A blood test, known as a radioallergosorbent test, is used to measure the amount of immunoglobulin E (IgE) antibodies. In simple words, this test helps detect sensitivity to specific types of mold.
Visual Contrast Sensitivity (VCS) Test
VCS test is not a diagnostic method, though it helps measure your ability to see details at low contrast, detect a contrast sensitivity deficit and the existence of other health-affecting processes.
Certain types of mold and mycotoxins can lead to a contrast sensitivity deficit. Therefore, positive results of the VCS test can be proof of possible exposure to mold.
Note: The VCS test is absolutely free, however, if you want a detailed report and interpretation of the results, you can give a small donation.
An Optimal Solution – MycoTOX Profile
Severe symptoms usually occur as a result of inhalation exposure or direct contact to mycotoxins and mycotoxin-containing molds. The Mycotoxins Test is the most comprehensive mycotoxin test that will help you identify fungal toxins and treat mold poisoning.
Unlike the spirometric test, skin prick test and blood test, mycotoxin testing provides clear answers and aids in diagnosing. It is also useful to do mycotoxin testing to make sure that detoxification therapy has been successful and recovery mold poisoning is going well.
MycoTOX can detect exposure to the following types of mold:
The Mycotoxin test measures 31 of the most common mycotoxins including:
For the Mycotoxin testing, all you have to do is to get 10 mL of the first-morning urine. Don’t eat or drink anything before getting the urine sample. Fasting for 12 hours is recommended for increased excretion of mycotoxins.
HLA-DR Testing For Mold Sensitivity

It happens quite often, that the entire family is experiencing recovery from mold toxicity, except for one person. Why is it so?
Mold allergy can be part of the problem, a bit like some people can eat peanuts while for other’s it can be life threatening.
The reason for your difficulty recovering from mold poisoning can be your genes, in particular, the HLA-DR gene. This gene lets mold toxins enter the brain, and start to slowly destroy neurons and disrupt hormone production.
For genetic testing to assess your susceptibility to environmental and food based mold I recommend the SelfDecode genetic test. The SelfDecode test has over 300 reports including detailed reports on mold toxicity.
Due to the neuronal loss and hormonal imbalances caused by the HLA-DR gene, the person usually has mold toxicity symptoms longer and it takes time to restore health. In some cases, full recovery never comes.
Moreover, carriers of the HLA-DR gene are more susceptible to other chronic diseases, including:
If the mold was removed, and you don’t feel better, HLA-DR testing is a must to prevent further complications and the development of life-threatening diseases.
Finally, the HLA-DR gene isn’t a death penalty, there is a way to control it. If the test results are positive, these are the two steps you have to take to better health:
Lifestyle Changes
Managing stress with yoga or meditation, minimum of 7 hours of sleep, high-intensity training for sweating and better excretion of toxins.
Nutritional Support
Anty-fungal diet and supplementation to augment the detoxification system.
If you need assistance in fighting mold toxicity and its symptoms, controlling your genes, improving your diet and lifestyle choices, you are welcome to schedule a consultation with me.
Are you looking for more information about How To Detox Your Body From Mold Toxicity? Read our guide for ways to detox your body from mold exposure!
Steps To Prevent Mold Growth
Spores are always floating in the air and it is extremely hard to prevent mold growth, yet it is possible to reduce the risks. Here are some tips on how to protect yourself from mold:
- Check for mold and mildew at least once in a year
- Keep your home dry and well ventilated, pay special attention to the bathroom, kitchen, garage, basement and laundry room
- Consider investing in dehumidifier for damp areas
- Fix any leaks and spills immediately
- Drain and unclog HVAC system regularly
- Make sure to leave your bathroom fan on for at least 20-30 minutes after showering
- Clean shower curtains and rugs regularly, if you’ve noticed mildew on the curtains, just replace them
- Open doors and windows after showering or while cooking to improve air flow
- Use air purifier with UV
If you have the symptoms of mold toxicity and you need help with a treatment plan to help eliminate the mold and regain your health – schedule a consultation.